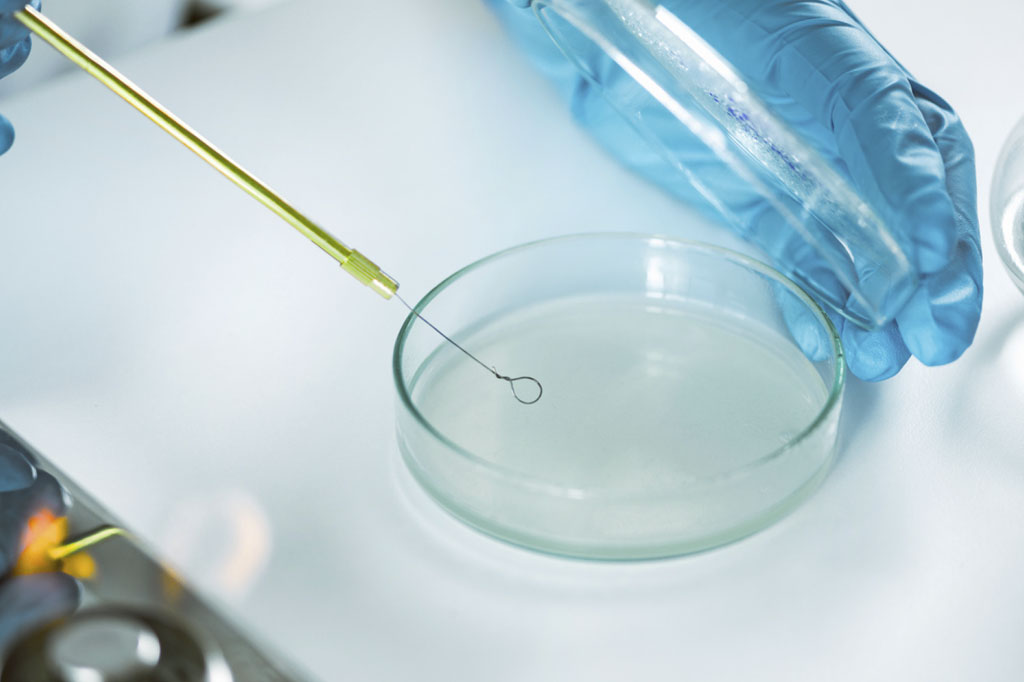

Bienvenido a IMDALAB, S.A.
Importadora de Artículos de Laboratorio e Industria
Te ofrecemos productos certificados, atención personalizada y entregas seguras en todo el país.

Quiénes Somos
Una empresa guatemalteca con visión de servicio
Distribuimos soluciones confiables para laboratorio e industria, con un enfoque en calidad, seguridad y eficiencia.
Soluciones confiables
Productos de alta calidad
Encuentra una amplia variedad de insumos diseñados para cumplir con los más altos estándares técnicos.
Tu mejor aliado
¿Por qué elegir a IMDALAB?
Atención directa y personalizada en todo momento
Te asesoramos de forma rápida y cercana en todo el proceso.
Productos importados con pruebas de calidad y respaldo
Garantía de seguridad, rendimiento y confiabilidad.

¿Tienes dudas o necesitas una cotización?
Estamos listos para ayudarte
Contáctanos fácilmente por llamada, mensaje o formulario. Nuestro equipo te dará una respuesta ágil y clara.








